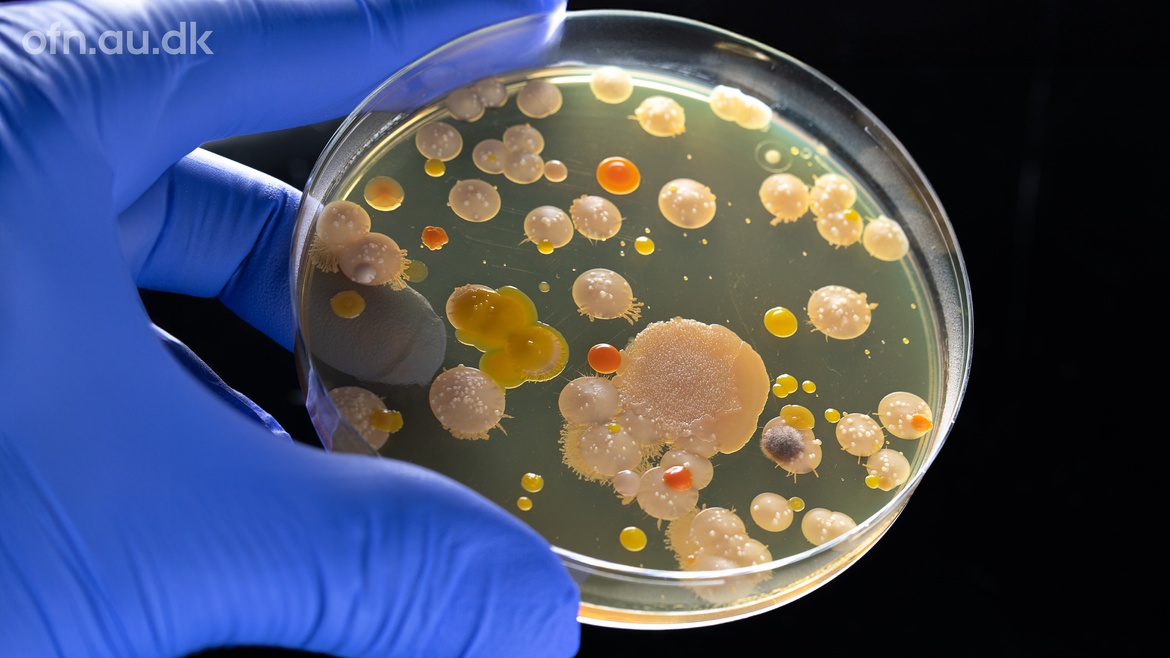

Foredrag | Livestream: Vil resistente bakterier slå os ihjel? (i Flensborg)
Bookingperioden for dette arrangement er slut.
Flensborg Bibliotek
Norderstr. 59
24939 Flensburg
Start:
Tilføj til kalender